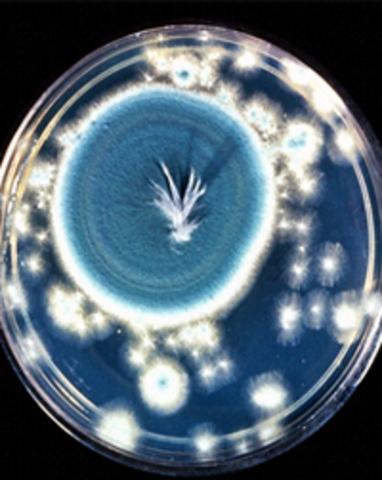
The Discovery
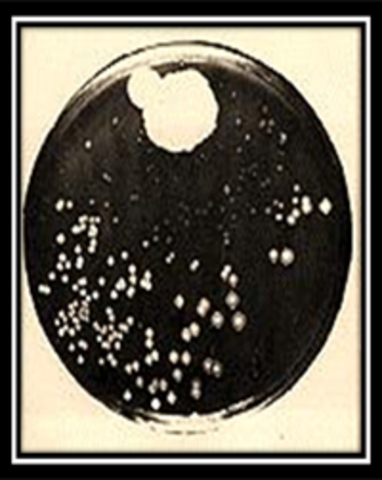
The name Penicillin

-
Alexander Fleming, discoverer of penicillin, is born near Lochfield, Scotland.
-
Howard Florey is born in Adelaide, Australia. He was important in the penicillin miracle.
-
Fleming qualified at St. Mary's Medical School and went on to study.
-
Ernest Chain, a German Jew, is born in Germany and is very important in the penicillin story.
-
In the end of September, Fleming began to notice that a mold, the Penicillum mold, had grown in a colony of bacteria, destroying some of it. He went on study it.
-
Fleming decides to call his "mold juice" Penicillin.
-
Howard Florey and Ernest Chain worked on penicillin mold (on the right) at the Oxford Univirsity and tried to find ways to purify and produce it.
-
World War 2 begins and penicillin is needed.
-
Albert Alexander was scratched from shaving and was badly infected. Howard Florey and his collleagues gave him penicillin. He got better, but they ran out and he died. This also proved penicillin worked.
-
Mass production of penicillin starts and is still going on today.
-
Alexander won the Nobel Prize in summer 1945 for his great discovery and shared with Howard Florey and Erenst Chain, who helped develop penicillin.
-
On March 15, 1955, Alexander Fleming died of a heart attack in London at age 73.
Plan projects on a visual timeline
Map milestones, phases, deadlines, and key events in one place so the sequence is easier to see and share. Timetoast is a timeline maker for work, school, research, and stories.